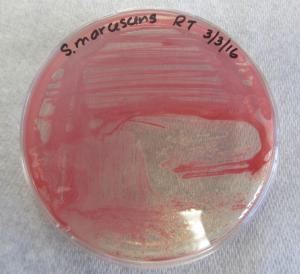

Darm-Mikrobiota schützt Honigbienen
Kommensale Mikroben im Darm helfen oft dabei, dass bakterielle Krankheitserreger keine Krankheit auslösen können. Eine Störung der Darm-Mikrobiota bei Honigbienen durch Antibiotika oder Agrochemikalien führt zu einer höheren Sterblichkeitsrate der Bienen, wenn sie auf das opportunistische Pathogen Serratia marcescens treffen.
